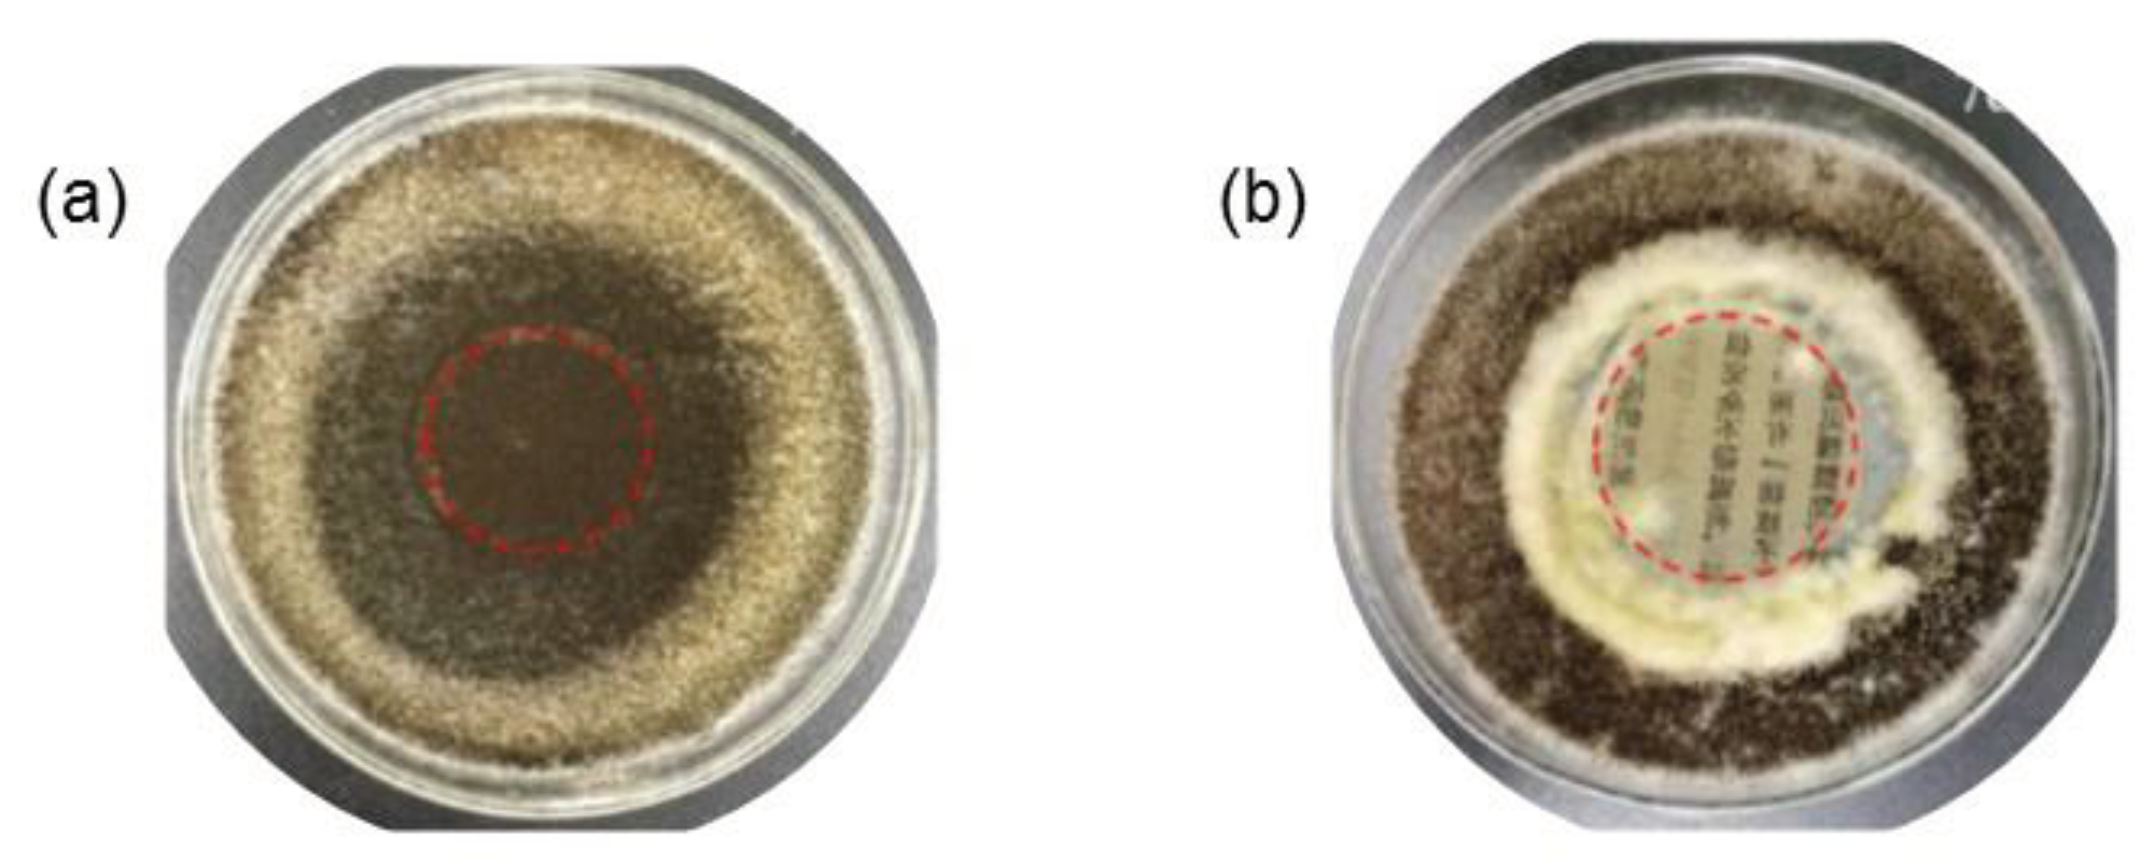

Submitted:
12 March 2024
Posted:
13 March 2024
You are already at the latest version
Abstract
Keywords:
1. Introduction
2. Cellulose and Its Isolation
3. Nanocelluloses
3.1. Cellulose Nanocrystals
3.1.1. Acid Hydrolysis
3.1.2. Enzymatic Hydrolysis
3.2. Cellulose Nanofibrils
3.2.1. Mechanical Methods
3.2.2. Combination of Methods
3.3. Bacterial Nanocellulose
3.4. Properties and Applications
4. Conservation and Restoration of Historical Documents
4.1. Iron Gall Ink
4.2. Conservation and Restoration Methods
4.2.1. Surface Cleaning
4.2.2. Deacidification
4.2.3. Japanese Paper
4.2.4. Calcium Phytate Method
5. Nanocelluloses in Historical Documents
6. Conclusions
Funding
Conflicts of Interest
References
- Almeida, R. O., Maloney, T. C., & Gamelas, J. A. F. (2023). Production of functionalized nanocelluloses from different sources using deep eutectic solvents and their applications. Industrial Crops & Products, 199, 1−30. [CrossRef]
- Antonelli, F., Galotta, G., Sidoti, G., Zikeli, F., Nisi, R., Davidde Petriaggi, B., & Romagnoli, M. (2020). Cellulose and lignin nano-scale consolidants for waterlogged archaeological wood. Frontiers in Chemistry, 8, 1−12. [CrossRef]
- Arantes, V., Dias, I. K. R., Berto, G. L., Pereira, B., Marotti, B. S.,& Nogueira, C. F. O. (2020). The current status of the enzyme-mediated isolation and functionalization of nanocelluloses: production, properties, techno-economics, and opportunities. Cellulose, 27, 10571–10630. [CrossRef]
- Aulin, C. (2009). Novel oil resistant cellulosic materials (pulp and paper technology). Sweden: KTH Chemical Science and Engineering.
- Baglioni, P., Chelazzi, D., & Giorgi, R. (2015). Nanotechnologies in the conservation of cultural heritage. Springer: Dordrecht. [CrossRef]
- Banik, G. (2009). Scientific conservation: transfer of scientific research on ink corrosion to conservation practice – does it take place? Restaurator, 131–146. [CrossRef]
- Bansa, H., & Ishii, R. (1997). The effect of different strengthening methods on different kinds of paper. Restaurator, 18, 51–72. [CrossRef]
- Baty, J. W., Maitland, C. L., Minter, W., Hubbe, M. A., & Jordan-Mowery, S. K. (2010). Deacidification for the conservation and preservation of paper-based works: a review. Bioresources, 5, 1955–2023. [CrossRef]
- Berlin, A., Balakshin, M., Gilkes, N., Kadla, J., Maximenko, V., Kubo, S., & Saddler, J. (2006). Inhibition of cellulase, xylanase and -glucosidase activities by softwood lignin preparations. Journal of Biotechnology, 125, 198–209. [CrossRef]
- Böhme, N., Anders, M., Reichelt, T., Schuhmann, K., Bridarolli, A., & Chevalier (2020). A. new treatments for canvas consolidation and conservation. Heritage Science, 8, 1−10. [CrossRef]
- Botti, L., Mantovani, O., & Ruggiero, D. (2005). Calcium phytate in the treatment of corrosion caused by iron gall inks: effects on paper. Restaurator, 44–62. [CrossRef]
- Bridarolli, A., Nechyporchuk, O., Odlyha, M., Oriola, M., Bordes, R., Holmberg, K., Anders, M., Chevalier, A., & Bozec, L. (2018). Nanocellulose-based materials for the reinforcement of modern canvas-supported paintings. Studies in Conservation. 63, 332–334. [CrossRef]
- Brinchi, L., Cotana, F., Fortunati, E., & Kenny, J. M. (2013). Production of nanocrystalline cellulose from lignocellulosic biomass: technology and applications. Carbohydrate Polymers, 94, 154–169. [CrossRef]
- Buchanan, S. A. (1987). The brittle book problem: approaches by research libraries in the United States. The Paper Conservator, 11, 69–72. [CrossRef]
- Camargos, C. H. M., Figueiredo Junior, J. C. D., & Pereira, F. V. (2017). Cellulose nanocrystal-based composite for restoration of lacunae on damaged documents and artworks on paper. Journal of Cultural Heritage, 23, 170–175. [CrossRef]
- Camargos, C. H. M., Poggi, G., Chelazzi, D., Baglioni, P., & Rezende, C. A. (2022). Protective coatings based on cellulose nanofibrils, cellulose nanocrystals, and lignin nanoparticles for the conservation of cellulosic artifacts. ACS Applied Nano Materials, 5, 13245−13259. [CrossRef]
- Cappitelli, F., Catto, C., & Villa, F. (2020) The control of cultural heritage microbial deterioration. Microorganisms, 8, 1542. [CrossRef]
- Cedzova, M., Gallova, I., & Katuscak, S. (2006). Patents for paper deacidification. Restaurator, 27, 35–45. [CrossRef]
- Choi, J.-I., Chung, Y. J., Kang, D. I., Lee, K. S., & Lee, J.-W. (2012). Effect of radiation on disinfection and mechanical properties of Korean traditional paper, Hanji. Radiation Physics and Chemistry, 81, 1051–1054. [CrossRef]
- Cunha, G. M. (1987). Mass deacidification for libraries. Library Technology Reports, 361–472.
- da Costa, A. C .A., Corrêa, F. N., Sant’Anna, G. S., Tonietto, G. B., Godoy, J. M. O., Gonçalves, R. A., & Lutterbach, M. T. S. (2016). Kinetic study of non-reactive iron removal from iron-gall inks. Chemical Papers, 70, 602–609. [CrossRef]
- de Amorim, J. D. P., de Souza, K. C., Duarte, C. R., Duarte, I. S., Ribeiro, F. A. S., Silva, G. S., de Farias, P. M. A., Stingl, A., Costa, A. F. S., Vinhas, G. M., & Sarubbo, L. A. (2020). Plant and bacterial nanocellulose: production, properties and applications in medicine, food, cosmetics, electronics and engineering: a review. Environmental Chemistry Letters, 18, 851-869. [CrossRef]
- Díaz Hidalgo, R. J., Cordoba, R., Nabais, P., Silva, V., Melo, M. J., Pina, F., Teixeira, N., & Freitas, V. (2018). New insights into iron-gall inks through the use of historically accurate reconstructions. Heritage Science, 6, 1–15. [CrossRef]
- Dreyfuss-Deseigne, R. (2017a). Nanocellulose films in art conservation: a new and promising mending material for translucent paper objects. Journal of Paper Conservation, 18, 18–29. [CrossRef]
- Dreyfuss-Deseigne, R. (2017b). A new mending material: nanocellulose film. Journal of Paper Conservation, 18, 36–37. [CrossRef]
- Dreyfuss-Deseigne, R. (2017c). Nanocellulose films: properties, development, and new applications for translucent and transparent artworks and documents in The Book and Paper Group Annual, 36, 108–114.
- Dufresne, A. (2013). Nanocellulose: a new ageless bionanomaterial. Materials Today, 16, 220–227. [CrossRef]
- Dufresne, A., & Belgacem, M. N. (2013). Cellulose-Reinforced Composites: from Micro-to Nanoscale. Polímeros, 23, 277–286. [CrossRef]
- Elmetwaly, T. E., Darwish, S. S, Attia, N. F, Hassan, R. R. A., El Ebissy, A. A., Eltaweil, A. S., Omer, A. M., El-Seedi, H. R., & Elashery, S. E. A. (2022). Cellulose nanocrystals and its hybrid composite with inorganic nanotubes as green tool for historical paper conservation. Progress in Organic Coatings, 168, 106890. [CrossRef]
- Fang, Z., Hou, G., Chen, C., & Hu, L. (2019). Nanocellulose-based films and their emerging applications. Current Opinion in Solid State & Materials Science, 23, 100764. [CrossRef]
- Ferrer, A., Pal, L., & Hubbe, M. (2017). Nanocellulose in packaging: advances in barrier layer technologies. Industrial Crops and Products, 95, 574–582. [CrossRef]
- Fornari, A., Rossi, M., Rocco, D., & Mattiello, L. (2022). A review of applications of nanocellulose to preserve and protect cultural heritage wood, paintings, and historical papers. Applied Sciences, 12, 1−31. [CrossRef]
- Ghasemi, S., Behrooz, R., & Ghasemi, I. (2016). Extraction and characterization of nanocellulose structures from linter dissolving pulp using ultrafine grinder. Journal of Nanoscience and Nanotechnology, 16, 5791–5797. [CrossRef]
- Gómez, N., Santos, S. M., Carbajo, J. M., & Villar, J. C. (2017). Use of bacterial cellulose in degraded paper restoration: effect on visual appearance of printed paper. BioResources, 12, 9130–9142. [CrossRef]
- Gopi, S., Balakrishnan, P., Chandradhara, D., Poovathankandy, D., & Thomas, S. (2019). General Scenarios of cellulose and its use in the biomedical field. Materials Today Chemistry, 13, 59–78. [CrossRef]
- Habibi, Y. (2014). Key advances in the chemical modification of nanocelluloses. Chemical Society Reviews, 43, 1519–1542. [CrossRef]
- He, X., Deng, H., & Hwang, H. (2019). The current application of nanotechnology in food and agriculture. Journal of Food and Drug Analysis, 27, 1–21. [CrossRef]
- Henniges, U., Angelova, L., Schwoll, S., Smith, H., & Brückle, I. (2022). Microfibrillated cellulose films for mending translucent paper: an assessment of film preparation and treatment application options. Journal of the Institute of Conservation, 45, 36–51. [CrossRef]
- Henniges, U., & Potthast, A. (2008). Phytate treatment of metallo-gallate inks: investigation of its effectiveness on model and historic paper samples. Restaurator, 29, 219–234. [CrossRef]
- Henniges, U., Reibke, R., Banik, G., Huhsmann, E., Hähner, U., Prohaska, T., & Potthast, A. (2008). Iron gall ink-induced corrosion of cellulose: aging, degradation and stabilization. Part 2: application on historic sample material. Cellulose, 15, 861–870. [CrossRef]
- Henriksson, M., & Berglund, L. A. (2007). Structure and properties of cellulose nanocomposite films containing melamine formaldehyde. Journal of Applied Polymer Science, 106, 2817–2824. [CrossRef]
- Hon, D. N.-S., & Shiraishi, N. (1991). Wood and Cellulosic Chemistry. New York: Marcel Dekker, Inc.
- Hubbe, M. A., Smith, R. D., Zou, X. J., Katuscak, S., Potthast, A., & Ahn, K. (2017). Deacidification of acidic books and paper by means of non-aqueous dispersions of alkaline particles: a review focusing on completeness of the reaction. Bioresources, 12, 4410–4477. [CrossRef]
- Ilyas, R. A., Sapuan, S. M., Ishak, M. R., Zainudin, E. S., & Atikah, M. S. N. (2018). Nanocellulose reinforced starch polymer composite: a review of preparation, properties and application in Proceedings of the 5th International Conference on Applied Sciences and Engineering Application (ICASEA, 2018). Capthorne Hotel, Cameron Highlands, Malaysia, 17.
- Iguchi, M., Yamanaka, S., & Budhiono, A. (2000). Bacterial cellulose a masterpiece of nature’s arts. Journal of Materials Science, 35, 261–270. [CrossRef]
- Jablonsky, M., Šima, J., & Lelovsky, M. (2000). Considerations on factors influencing the degradation of cellulose in alumrosin sized paper. Carbohydrate Polymers, 245, 116534. [CrossRef]
- Jacobi, E., Reissland, B., Luu, C. P. T., van Velzen, B., & Ligterink, F. (2011). Rendering the invisible visible: preventing solvent-induced migration during local repairs on iron gall ink. Journal of Paper Conservation, 12, 25–34.
- Jia, M., Zhanga, X., Wenga, J., Zhanga, J., & Zhang, M. (2017). Protective coating of paper works: ZnO/cellulose nanocrystal composites and analytical characterization. Journal of Cultural Heritage, 38, 64–74. [CrossRef]
- Kargarzadeh, H., Ahmad, I., Thomas, S., & Dufresne, A. (2017). Handbook of nanocellulose and cellulose nanocomposites. Weinheim: John Wiley & Sons.
- Kargarzadeh, H., Mariano, M., Gopakumar, D., Ahmad, I., Thomas, S., Dufresne, A., Huang, J., & Lin, N. (2018). Advances in cellulose nanomaterials. Cellulose, 25, 2151–2189. [CrossRef]
- Kaur, P., Sharma, N., Munagala, M., Rajkhowa, R., Aallardyce, B., Shastri, Y., & Agrawal, R. (2021). Nanocellulose: resources, physio-chemical properties, current uses and future applications. Frontiers in Nanotechnology, 3, 1−17. [CrossRef]
- Keerati-U-Rai, M., & Corredig, M. (2009). Effect of dynamic high Pressure homogenization on the aggregation state of soy protein. Journal of Agricultural and Food Chemistry, 57, 3556–3562. [CrossRef]
- Klemm, D., Kramer, F., Moritz, S., Lindström, T., Ankerfors, M., Gray, D., & Dorris, A. (2011). Nanocelluloses: a new family of nature-based materials. Angewandte Chemie International Edition, 50, 5438−5466. [CrossRef]
- Klemm, D., Schumann, D., Kramer, F., Hessler, N., Hornung, M., Schmauder, H. P., & Marsch, S. (2006). Nanocelluloses as innovative polymers in research and application. Polysaccharides, 205, 49−96. [CrossRef]
- Kolar, J., & Strlic, M. (2006). Iron gall inks: on manufacture, characterisation, degradation and stabilisation. Ljubljana: National and University Library of Slovenia.
- Kolbe G. (2004). Gelatine in historical paper production and as inhibiting agent for iron-gall ink corrosion on paper. Restaurator, 25, 26–39. [CrossRef]
- Kumar, V., Pathak, P., & Bhardwaj, N. K. (2020). Waste paper: an underutilized but promising source for nanocellulose mining. Waste Management, 102, 281–303. [CrossRef]
- Kumar, R., Rai, B., Gahlyan, S., & Kumar, G. (2021). A comprehensive review on production, surface modification and characterization of nanocellulose derived from biomass and its commercial applications. Express Polymer Letters, 15, 104–120. [CrossRef]
- Lavoine, N., Desloges, I., Dufresne, A., & Bras, J. (2012). Microfibrillated cellulose – its barrier properties and applications in cellulosic materials: a review. Carbohydrate Polymers, 90, 735–764. [CrossRef]
- Lee, S. Y., Baty, J., & Minter, W. (2010). Study of the aging behavior of rosin-alum sized papers by analysis of mechanical strength, optical properties, and chemical composition following accelerated aging. The Book and Paper Group Annual, 29, 127–128.
- Li, A., Xu, D., Luo, L., Zhou, Y., Yan, W., Leng, X., Dai, D., Zhou, Y., Ahmad, H., Rao, J., & Fan, M. (2021). Overview of nanocellulose as additives in paper processing and paper products. Nanotechnology Reviews, 10, 264–281. [CrossRef]
- Li, F., Mascheroni, E., & Piergiovanni, L. (2015). The potential of nanocellulose in the packaging field: a review. Packaging Technology and Science, 28, 475−508. [CrossRef]
- Liu, W., Du, H., Zhang, M., Liu, K., Liu, H., Xie, H., Zhang, X., & Chuanling, S. (2020). Bacterial cellulose-based composite scaffolds for biomedical applications: a review. ACS Sustainable Chemistry & Engineering, 8, 7536–7562. [CrossRef]
- Liu, W., Liu, K., Du, H., Zheng, T., Zhang, N., Xu, T., Pang, B., Zhang, X., Si, C., & Zhang, K. (2022). Cellulose nanopaper: fabrication, functionalization, and applications. Nano-Micro Letters, 14, 104. [CrossRef]
- Liu, J., Xing, H., Wang, J., Cao, J., Chao, X., Jia, Z., & Li, Y. (2021). A new reinforcement method for the conservation of fragile, double-sided, printed paper cultural relics. Heritage Science, 9, 123. [CrossRef]
- Liu, D., Zhong, T., Chang, P. R., Li, K., & Wu, Q. (2010). Starch composites reinforced by bamboo cellulosic crystals. Bioresource Technology, 101, 2529–2536. [CrossRef]
- Ma, X., Tian, S., Li, X., Fan, H., & Fu, S. (2021). Combined polyhexamethylene guanidine and nanocellulose for the conservation and enhancement of ancient paper. Cellulose, 28, 8027–8042. [CrossRef]
- Ma, X., Zhu, Z., Zhang, H., Tian, S., Li, X., Fan, H., & Fu, S. (2022). Superhydrophobic and deacidified cellulose/CaCO3-derived granular coating toward historic paper preservation. International Journal of Biological Macromolecules, 207, 232–241. [CrossRef]
- Malešič, J., Marinsek, M., & Cigic, I. K. (2022). Evaluation of bookkeeper mass deacidification based on historical book papers. Cellulose, 29, 6889–6905. [CrossRef]
- Mateo, S., Peinado, S., Morillas-Gutiérrez, F., La Rubia, M. D., & Moya, A. J. (2021). Nanocellulose from agricultural wastes: products and applications – a review. Processes, 9, 1594. [CrossRef]
- Melo, M. J., Otero, V., Nabais, P., Teixeira, N., Pina, F., Casanova, C., Fragoso, S., & Sequeira, S. O. (2022). Iron-gall inks: a review of their degradation mechanisms and conservation treatments. Heritage Science, 10, 145. [CrossRef]
- Milwich, M., Speck, T., Speck, O., Stegmaier, T., & Planck, H. (2006). Biomimetics and technical textiles: solving engineering problems with the help of nature’s wisdom. American Journal of Botany, 93, 1455−1465. [CrossRef]
- Mishra, R. K., Sabu, A., & Tiwari, S. K. (2018). Materials chemistry and the futurist eco-friendly applications of nanocellulose: status and prospect. Journal of Saudi Chemical Society, 22, 949–978. [CrossRef]
- Missoum, K., Belgacem, M., & Bras, J. (2013). Nanofibrillated cellulose surface modification: a review. Materials, 6, 1745–1766. [CrossRef]
- Mokhena, T. C., & John, M. J. (2020). Cellulose nanomaterials: new generation materials for solving global issues. Cellulose, 27, 1149–1194. [CrossRef]
- Mondal, S. (2017). Preparation, properties and applications of nanocellulosic materials. Carbohydrate Polymers, 163, 301–316. [CrossRef]
- Nandi, S., & Guha, P. (2018). A review on preparation and properties of cellulose nanocrystal-incorporated natural biopolymer. Journal of Packaging Technology and Research, 2, 149–166. [CrossRef]
- Nasir, M., Hashim, R., Sulaiman, O., & Asim, M. (2017). Nanocellulose: preparation methods and applications in Cellulose-Reinforced Nanofibre Composites. Elsevier. [CrossRef]
- Nechyporchuk, O., Belgacem, M. N., & Bras, J. (2016). Production of cellulose nanofibrils: a review of recent advances. Industrial Crops and Products, 93, 2–25. [CrossRef]
- Nechyporchuk, O., Kolman, K., Bridarolli, A., Odlyha, M., Bozec, L., Oriola, M., Campo-Francés, G., Persson, M., Holmberg, K., & Bordes, R. (2018). On the potential of using nanocellulose for consolidation of painting canvases. Carbohydrate Polymers, 194, 161–169. [CrossRef]
- Neevel J. (1995). The development of a new conservation treatment for ink corrosion, based on the natural anti-oxidant phytate in Conference Papers, 8th Congress of, IADA. Tubingen: IADA.
- Neevel, J. G., & Mensch, C. T. J. (1999). The behaviour of iron and sulphuric acid during iron-gall ink corrosion in COM Committee for Conservation 12th Trienn Meet Lyon.
- Oksman, K., Aitomäki, Y., Mathew, A. P., Siqueira, G., Zhou, Q., Butylina, S., Tanpichai, S., Zhou, X., & Hooshmand, S. (2016). Review of the recent developments in cellulose nanocomposite processing. Composites Part A: Applied Science and Manufacturing, 83, 2–18. [CrossRef]
- Operamolla, A., Mazzuca, C., Capodieci, L., Di Benedetto, F., Severini, L., Titubante, M., Martinelli, A., Castelvetro, V., & Micheli, L. (2021). Toward a reversible consolidation of paper materials using cellulose nanocrystals. ACS Applied Materials & Interfaces, 13, 44972–44982. [CrossRef]
- Pecoraro, É., Manzani, D., Messaddeq, Y., & Ribeiro, S. J. L. (2008). Bacterial cellulose from Glucanacetobacter xylinus: preparation, properties and applications in Monomers, Polymers and Composites from Renewable Resources. Elsevier.
- Perdoch, W., Cao, Z., Florczak. P., Markiewicz, R., Jarek, M., Olejnik, K., & Mazela. B. (2022). Influence of nanocellulose structure on paper reinforcement. Molecules, 27, 4696. [CrossRef]
- Petroudy, S. R. D., Chabot, B., Loranger, E., Naebe, M., Shojaeiarani, J., Gharehkhani, S., Ahvazi, B., Hu, J., & Thomas, S. (2021). Recent advances in cellulose nanofibers preparation through energy-efficient approaches: a review. Energies, 14, 6792. [CrossRef]
- Phanthong, P., Reubroycharoen, P., Hao, X., Xu, G., Abudula, A., & Guan, G. (2018). Nanocellulose: extraction and application. Carbon Resources Conversion, 1, 32–43. [CrossRef]
- Poulose, A., Parameswaranpillai, J., George, J. J., Gopi, J. A., Krishnasamy, S., Dominic C. D. M., Hameed, N., Salim, N. V., Radoor, S., & Sienkiewicz, N. (2022). Nanocellulose: a fundamental material for science and technology applications. Molecules, 27, 1-27. [CrossRef]
- Punnadiyil, R. K., Sreejith, M., & Purushothaman, E. (2016). Isolation of microcrystalline and nano cellulose from peanut shells. Journal of Chemical and Pharmaceutical Sciences, 974, 12–16.
- Rajinipriya, M., Nagalakshmaiah, M., Robert, M., & Elkoun, S. (2018). Importance of agricultural and industrial waste in the field of nanocellulose and recent industrial developments of wood based nanocellulose: a review. ACS Sustainable Chemistry & Engineering, 6, 2807–2828. [CrossRef]
- Rambabu, N., Panthapulakkal, S., Sain, M., Dalai, A., & Dalai, K. (2016). Production of nanocellulose fibers from pinecone biomass: evaluation and optimization of chemical and mechanical treatment conditions on mechanical properties of nanocellulose films. Industrial Crops and Products, 83, 746–754. [CrossRef]
- Reißland, B., & Graaff, J. H. (2001). Condition rating for paper objects with iron gall ink in ICN-Information Instituut Collectie Nederland. Amsterdam: Netherlands Institute for Cultural Heritage.
- Reissland, B. (2000). Visible progress of paper degradation caused by iron gall inks in The Iron Gall Ink Meeting. Newcastle upon Tyne: University of Northumbria.
- Reissland, B. (2001). Ink corrosion: side-effects caused by aqueous treatments for paper objects in The Iron Gall Ink Meeting. Newcastle upon Tyne: University of Northumbria.
- Rouchon, V., Desroches, M., Duplat, V., Letouzey, M., & Stordiau-Pallot, J. (2012). Methods of aqueous treatments: the last resort for badly damaged iron gall ink manuscripts. Journal of Paper Conservation, 13, 7–13.
- Rouchon, V., Pellizzi, E., Duranton, M., Vanmeert, F., & Janssens, K. (2011). Combining XANES, ICP-AES and SEM/EDS for the study of phytate chelating treatments used on iron gall ink damaged manuscripts. Journal of Analytical Atomic Spectrometry, 26, 2434–2441. [CrossRef]
- Saito, T., Kimura, S., Nishiyama, Y., & Isogai, A. (2007). Cellulose nanofibers prepared by TEMPO-mediated oxidation of native cellulose. Biomacromolecules, 8, 2485–2491. [CrossRef]
- Sánchez Hernampérez, A. (1999). Políticas de conservación en bibliotecas. Arco Libros, Madrid.
- Santos, S. M., Carbajo, J. M., Gómez, N., Quintana, E., Ladero, M., Sánchez, A., Chinga-Carrasco, G., & Villar, J. C. (2016a). Use of bacterial cellulose in degraded paper restoration. Part I: application on model papers. Journal of Materials Science, 51, 1541–1552. [CrossRef]
- Santos, S. M., Carbajo, J. M., Gómez, N., Quintana, E., Ladero, M., Sánchez, A., Chinga-Carrasco, G., & Villar, J. C. (2016b). Use of bacterial cellulose in degraded paper restoration. Part II: application on real samples. Journal of Materials Science, 51, 1553–1561. [CrossRef]
- Scholten, S. (1997) in Proceedings of the European Workshop on Iron-Gall Ink Corrosion. Instituut Collectie Nederland, Amsterdam.
- Sharma, A., Thakur, M., Bhattacharya, M., & Mandal, T. (2019). Commercial application of cellulose nano-composites – a review. Biotechnology Reports, 21, 1-15. [CrossRef]
- Siqueira, G., Bras, J., & Dufresne, A. (2010). Cellulosic bionanocomposites: a review of preparation, properties and applications. Polymer, 2, 728–765. [CrossRef]
- Sobucki, W., & Drewniewska-Idziak, B. (2003). Survey of the preservation status of the 19th and 20th century collections at the national library in Warsaw. Restaurator, 24, 189–201. [CrossRef]
- Spence, K. L., Venditti, R. A., Rojas, O. J., Habibi, Y., & Pawlak, J. J.(2011). A comparative study of energy consumption and physical properties of microfibrillatedcellulose produced by different processing methods. Cellulose, 18, 1097–1111. [CrossRef]
- Suryanegara, L., Nakagaito, A. N., & Yano, H. (2010). Thermo-mechanical properties of microfibrillated cellulose-reinforced partially crystallized PLA composites. Cellulose, 17, 771–778. [CrossRef]
- Thomas, B., Raj, M. C., Athira, K. B., Rubiyah, M. H., Joy, J., Moores, A., Drisko, G. L., & Sanchez, C. (2018). Nanocellulose, a versatile green platform: from biosources to materials and their applications. Chemical Reviews, 118, 11575−11625. [CrossRef]
- Thomas, S. K., Begum, S., Midhun Dominic, C. D., Salim, N. V.; Hameed, N., Rangappa, S. M., Siengchin, S., & Parameswaranpillai, J. (2021). Isolation and characterization of cellulose nanowhiskers from Acacia caesia plant. Journal of Applied Polymer Science, 138, 50213. [CrossRef]
- Tkalčec, M. M., Bistričić, L., & Leskovac, M. (2016). Influence of adhesive layer on the stability of kozo paper. Cellulose, 23, 853–872. [CrossRef]
- Trache, D., Tarchoun, A. F., Derradji, M., Mehelli, O., Hussin, M. H., & Bessa, W. (2020a). Cellulose fibers and nanocrystals: preparation, characterization and surface modification in Functionalized Nanomaterials I: Fabrication. Taylor & Francis.
- Trache, D., Tarchoun, A. F., Derradji, M., Hamidon, T. S., Masruchin, N., Brosse, N., & Hussin, M. H. (2020b). Nanocellulose: from fundamentals to advanced applications. Frontiers in Chemistry, 8, 1–33. [CrossRef]
- Thomas, B., Raj, M. C., Athira K. B., Rubiyah M. H., Joy, J., Moores A., Drisko, G. L. & Sanchez, C. (2018). Nanocellulose, a versatile green platform: from biosources to materials and their applications. Chemical Reviews, 118, 11575−11625.
- Van Gulik, R., & Kersten, P. (1994). Closer look at iron gall ink burn. Restaurator, 15, 173–178.
- Vanderfleet, O. M. & Cranston, E. D. (2021). Production routes to tailor the performance of cellulose nanocrystals. Nature Reviews Materials, 6, 124–144. [CrossRef]
- Vazquez, A., Foresti, M. L., Moran, J. I., & Cyras, V. P. (2015). Extraction and production of cellulose nanofibers in Handbook of Polymer Nanocomposites. Processing, Performance and Application. Springer: Heidelberg.
- Vineeth, S., Gadhave, R. V., & Gadekar, P. T. (2019). Chemical modification of nanocellulose in wood adhesive. Open Journal of Polymer Chemistry, 9, 86–99. [CrossRef]
- Völkel, L., Ahn, K., Hähner, U., Gindl-Altmutter, W., & Potthast, A. (2017). Nano meets the sheet: adhesive-free application of nanocellulosic suspensions in paper conservation. Heritage Science, 5, 23. [CrossRef]
- Völkel, L., Prohaska, T., & Potthast, A. (2020). Combining phytate treatment and nanocellulose stabilization for mitigating iron gall ink damage in historic papers. Heritage Science, 8, 86. [CrossRef]
- Völkel, L., Beaumont, M., Johansson, L.-S., Czibula, C., Rusakov, D., Mautner, A., Teichert, C., Kontturi, E., Rosenau, T, &; Potthast, A. (2022). Assessing fire-damage in historical papers and alleviating damage with soft cellulose nanofibers. Small, 18, 2105420. [CrossRef]
- Wang, S., & Cheng, Q. (2009). A novel process to isolate fibrils from cellulose fibers by high-intensity ultrasonication. Part 1: process optimization. Journal of Applied Polymer Science, 113, 1270–1275. [CrossRef]
- Wang, Z., Cheng, C., Cheng, Y., Zheng, L., & Hu, D. (2021). Quaternary alloy quantum dots as fluorescence probes for total acidity detection of paper-based relics. Nanomaterials, 11, 1726. [CrossRef]
- Wang, Q., Yao, Q., Liu, J., Sun, J., Zhu, Q., & Chen, H. (2019). Processing nanocellulose to bulk materials: a review. Cellulose, 26, 7585–7617. [CrossRef]
- Wertz, J. L., Mercier, J. P., & Bédué, O. (2010). Cellulose Science and Technology. Lausanne: CRC Press.
- Xu, J., Zhang, T., Jiang, Y., Yang, D., Qiu, F., Chen, Q., & Yu, Z. (2020). Preparation of self-healing acrylic copolymer composite coatings for application in protection of paper cultural relics. Polymer Engineering & Science, 60, 288–296. [CrossRef]
- Zervos, S., & Alexopoulou, I. (2015). Paper conservation methods: a literature review. Cellulose, 22, 2859–2897. [CrossRef]
- Zhang, X, Yan, Y., Yao, J., Jin, S., & Tang, Y. (2003). Chemistry directs the conservation of paper cultural relics. Polymer Degradation and Stability, 207, 110228. [CrossRef]
- Zyska, B. (1996). Permanence of paper in Polish books of the period 1900-1994. Restaurator, 17, 214–228. [CrossRef]

| Properties/Applications | Cellulose Nanocrystals | Cellulose Nanofibrils | Bacterial Nanocellulose | |
|---|---|---|---|---|
|
Morphology (Liu et al., 2022) |
 |
 |
 |
|
| Preparation Process (Iguchi et al., 2000) | top-down | top-down | bottom-up | |
| Size (Thomas et al., 2018) |
Length (nm) | 50 – 500 | > 1,000 | 1,000 – 5,000 |
| Diameter (nm) | 3 – 50 | 5 – 100 | < 100 | |
| Crystallinity Index (%) (Ilyas et al., 2018) | 54 – 88 | < 50 | > 88 | |
| Young’s Modulus (GPa) (de Amorim et al., 2020) | 50 – 100 | 39 – 78 | 15 – 30 | |
| Purity (Pecoraro et al. 2008) | low | low | high | |
| Cost (Thomas et al., 2018) | low | low | high | |
| Main Applications (Thomas et al., 2018) |
optical devices, composite materials and coatings | packaging, energy storage and flexible electronics | antimicrobial products and flexible supercapacitors | |
| Nanocellulose-Based Material | Document Type | Application Methodology | General Results | Reference |
|---|---|---|---|---|
| Bacterial cellulose | Books from 1940 to 1960 | Layer (wheat starch as adhesive) |
High stability over time Lower air permeability Similar mechanical properties Better legibility of the letters Improvement in deteriorated paper quality Adequate protection against humidity and atmospheric pollutants |
Santos et al., 2016b |
| Bacterial cellulose and a mechanically nanofibrillated cellulose | Rag papers from the nineteenth century Book paper from the twentieth century |
Suspension (no adhesive) |
Treatment of mechanical damage areas Consolidation of weakened areas No negative side effects in long term |
Völkel et al., 2017 |
| Cellulose nanocrystals/zinc oxide | School newspaper from 1960 | Suspension (Klucel as adhesive) |
Improvement in mechanical properties Stronger antibacterial and antifungal activity High protection against UV light |
Jia et al., 2017 |
| Cellulose nanocrystals/propylene glycol/methylcellulose/calcium carbonate | Two paper sheets from a bookprinted in twentieth century | Sheet (methylcellulose asinternal sizing agent) |
High crystallinity index Mild basic character Similar mechanical properties |
Camargos et al., 2017 |
| Microfibrillated cellulose | Paper viewing slides from the mid nineteenth century | Film (wheat starch paste, methylhydroxyethylcellulose MH300P®, Klucel G® and Culminal MC2000® as adhesives) |
Very thinner Remarkable properties of transparency Very good stability to light, temperature and humidity aging Good results with Klucel G® |
Dreyfuss-Deseigne, 2017a, 2017b, 2017c |
| Calcium phytate/calcium hydrogen carbonate treatment combined with nanofibrillated cellulose | Rag papers written with iron gall ink from a collection of sermonsbelonging to 1839 and 1840 | Suspension (no adhesive) |
Viable combined procedure of chemical and mechanical stabilization Closed and sealed of fractures, cracks and imperfections Minimal influence on the optical and haptic properties Additional step avoided (stabilization and drying) |
Völkel et al., 2020 |
| Sulfated and neutral cellulose nanocrystals | Book from the eighteen century | Suspension (no adhesive) |
Improvement in optical and mechanical properties Safer neutral cellulose nanocrystals |
Operamolla et al., 2021 |
| Cellulose nanocrystals/polyhexamethylene guanidine | Book published in 1954 | Suspension (no adhesive) |
Excellent biocidal activity against mold Improvement in mechanical properties Outstanding performance in aging tests |
Ma et al., 2021 |
| Microfibrillated cellulose/methycellulose | Volume with designs dating from 1859 to 1882 | Film (methycellulose as internal adhesive and Klucel® G and IG Isinglass as adhesives) |
Best combination with Klucel G® Potential for customization Satisfactory transparency High strength after adhesion Stable aging properties |
Henniges et al., 2022 |
| Cellulose nanofiber | Fire-damaged historical papers from eighteenth and early nineteenth century | Suspension (no adhesive) |
No negative visual impact Mechanical stabilization in long-term to reduce paper fragility |
Völkel et al., 2022 |
| Cellulose nanocrystals/calcium carbonate/polydimethylsiloxane (superhydrophobic self-cleaning coating | Book published in 1954 | Suspension (no adhesive) |
Increase in thickness, water contact angle and roughness Improvement in mechanical strength Achievement superhydrophobic protection Excellent properties of self-cleaning and deacidification effect |
Ma et al., 2022 |
| Cellulose nanocrystals/inorganic nanotubes (multifunctional protective coatings) | Historical paper produced in 1943 | Colloidal solution (no adhesive) |
Improvement in tensile strength, elongation at break, thermal stability and UV protection without altering optical properties | Elmetwaly et al., 2022 |
Disclaimer/Publisher’s Note: The statements, opinions and data contained in all publications are solely those of the individual author(s) and contributor(s) and not of MDPI and/or the editor(s). MDPI and/or the editor(s) disclaim responsibility for any injury to people or property resulting from any ideas, methods, instructions or products referred to in the content. |
© 2024 by the authors. Licensee MDPI, Basel, Switzerland. This article is an open access article distributed under the terms and conditions of the Creative Commons Attribution (CC BY) license (http://creativecommons.org/licenses/by/4.0/).




